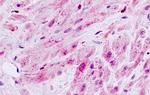
MLK1 Antibody in Immunohistochemistry (Paraffin) (IHC (P))

Search
Invitrogen
MLK1 Polyclonal Antibody
{{$productOrderCtrl.translations['antibody.pdp.commerceCard.promotion.promotions']}}
{{$productOrderCtrl.translations['antibody.pdp.commerceCard.promotion.viewpromo']}}
{{$productOrderCtrl.translations['antibody.pdp.commerceCard.promotion.promocode']}}: {{promo.promoCode}} {{promo.promoTitle}} {{promo.promoDescription}}. {{$productOrderCtrl.translations['antibody.pdp.commerceCard.promotion.learnmore']}}
产品信息
PA1-32636
宿主/亚型
分类
类型
抗原
偶联物
形式
浓度
规格
保存条件
运输条件
RRID
产品详细信息
PA1-32636 detects MLK1 from human samples.
PA1-32636 has been successfully used in immunohistochemistry (paraffin tissue) applications.
The PA1-32636 immunogen is: Synthetic peptide, KLH conjugated.
靶标信息
MAP3K9 (MLK1) is a serine/threonine protein kinase that functions in the MAP kinase pathway. Plays an important role in the cascades of cellular responses evoked by changes in the environment. Once activated, acts as an upstream activator of the MKK/JNK signal transduction cascade through the phosphorylation of MAP2K4/MKK4 and MAP2K7/MKK7 which in turn activate the JNKs. The MKK/JNK signaling pathway regulates stress response via activator protein-1 (JUN) and GATA4 transcription factors. Plays also a role in mitochondrial death signaling pathway, including the release cytochrome c, leading to apoptosis.
仅用于科研。不用于诊断过程。未经明确授权不得转售。